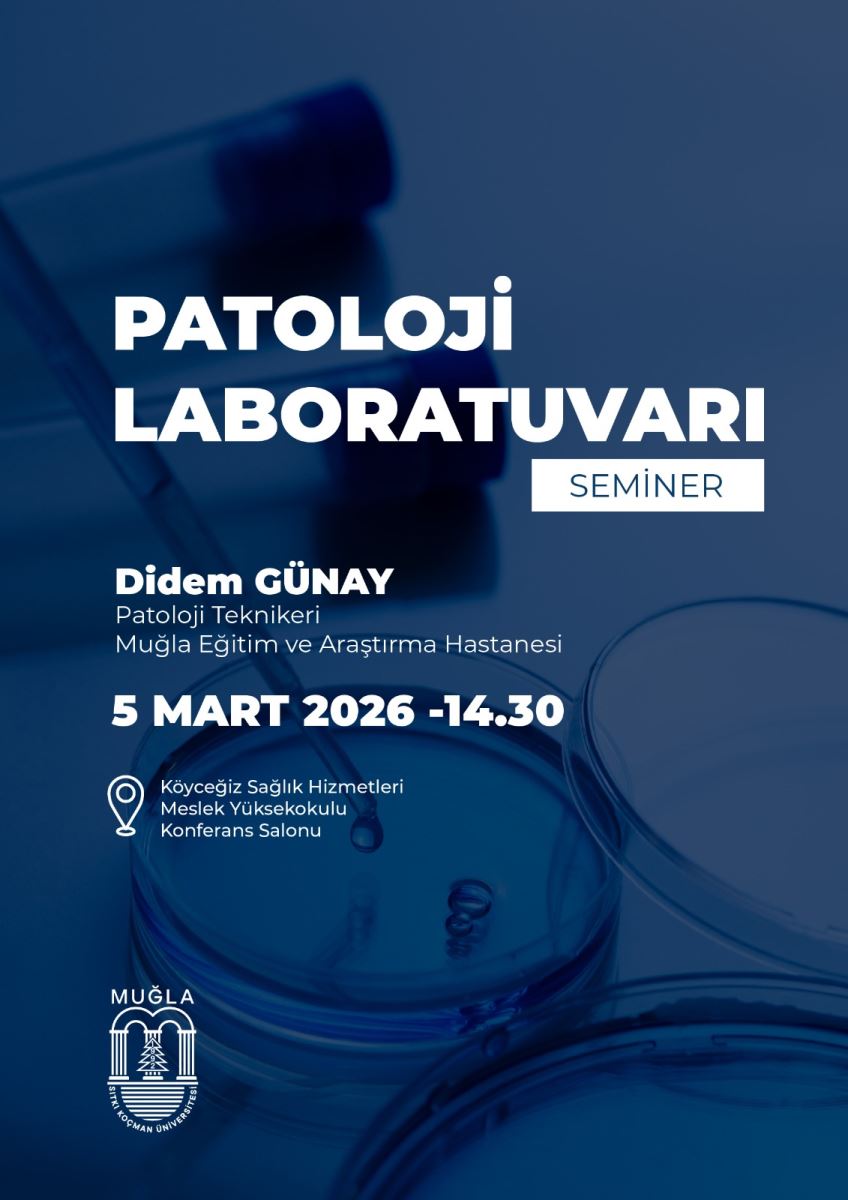

Muğla Sıtkı Koçman Üniversitesi Köyceğiz Sağlık Hizmetleri Meslek Yüksekokulu Tıbbi Laboratuvar Teknikleri Programı tarafından düzenlenen bilgilendirme etkinliğinde, Sağlık Teknikeri Didem GÜNAY patoloji laboratuvarının işleyişine ilişkin yüz yüze sunum ve söyleşi gerçekleştirecektir. Etkinlik kapsamında patoloji laboratuvarında örnek kabul süreci, doku takibi (fiksasyon–takip–bloklama), kesit alma, boyama (H&E ve genel uygulamalar), iş sağlığı ve güvenliği ile laboratuvarda görev ve sorumluluklar gibi başlıklar ele alınacak; ayrıca öğrencilerin sorularının yanıtlanacağı bir soru–cevap bölümü yer alacaktır. Etkinlik, 5 Mart Perşembe günü saat 14.30’da Köyceğiz Sağlık MYO Konferans Salonu’nda gerçekleştirilecek olup Tıbbi Hizmetler ve Teknikler Bölümü, Tıbbi Laboratuvar Teknikleri Programı öğrencileri davetlidir.
Koordinatör: Öğr.Gör. İlknur TINDAŞ